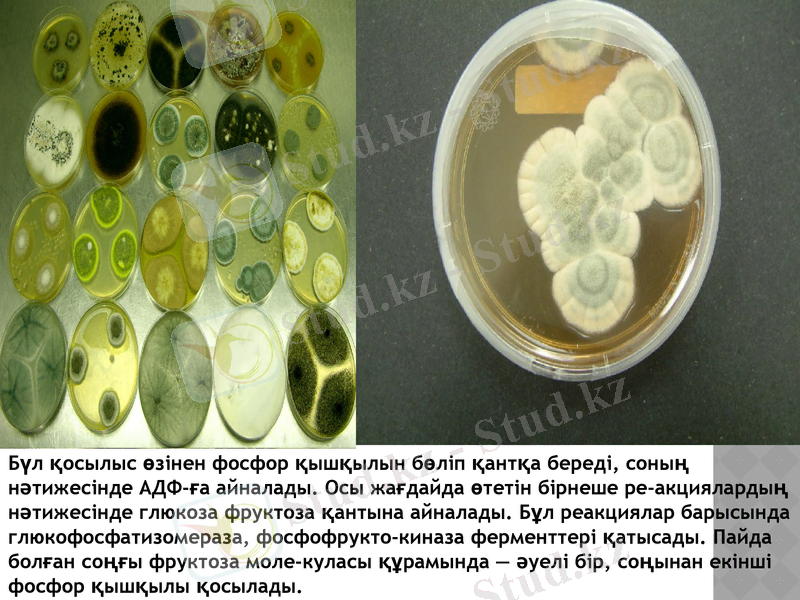
Slide 6

Спирттік ашытуда микроорганизмдердің рөлі және биохимиялық негіздері



Спирттік ашытуда микроорганизмдерді қолдану
Орындаған: Асен Т
Тобы: БТ-307
Тексерген: Қабденова А. Т.

Спирттік ашу процесі. Ашытқы саңырауқұлақтардың көмегімен қантты заттарды; спиртке және кәмір қышқыл газына айналуын спирттік ашу процесі деп атайды. Ол мына темендегі реакцияға сай жүреді.

Мұндағы АДФ деп отырғанымыз аденозин дифосфорлы қышқыл, ал АТФ - аденозин три фосфор қышқылы. Бұл қосылыстар - энергияға бай химиялық заттар. Ашу процесі барысында осы заттардың көмегімен ашытқы саңырауқұлақтар энергия алып, бұл процесті әрі қарай жүргізіп отырады. Негізінен спирттік ашу процесіне сахаромицет тобына жататын ашытқы саңырауқұлақтар қатынасады. Мұнда этил спирті мен көмір қышқыл газынан басқа да қосымша заттар түзіледі. Оларға: сірке альдегиді, глицерин, сірке және янтарь қышқылдары, сивуш майлары жатады. Сивуш майларының түзілуі ортадағы амин қыш-қылдарының ыдырауына байланысты. Амин қышқылдарынан пайда болған аммиакпен ашытқы саңырауқүлақтар қоректенеді де ортада сивуш майлары жинала береді. Ашытқы саңырауқүлақтар-мен катар, кейбір мукор тобына жататын зең саңырауқүлақтар мен бактерияларда спирттік ашу процесін жүргізеді. Алайда олардың әрекетіңен пайда болған спирт мөлшері, ашытқы саңырауқүлақтарды қолданғандағыға қарағанда, анағұрлым аз болады.

Ашытқы саңырауқүлақтар ашудың жағдайларына байланысты ортада әр түрлі заттар түзеді. Олардың ішінде басым көпшілігі этил спирті мен көмір қышқыл газы болады, кейде глицерин мен сірке қышқылы кездеседі. Ашытқы саңырауқүлақтар кез келген қанттарды ашытпай, тек моносахаридтер мен дисахаридтерді ғана ашытады. Полисахаридтерді, мәселен крахмалды, олар ашыта алмайды. Мүның себебі: ашытқы саңырауқүлақтарда амилаза ферменті болмайды. Сондықтан крахмалды өндірісте алдын ала түрлі ферменттер көмегімен моно және дисахаридтерге дейін ажы-ратып алады. Ал ашытқы саңырауқүлақтар клеткасында болатын мальтаза ферменті дисахарид мальтозаны глюкозаға айналдырады. Глюкозадан зимаза ферменттерінің көмегімен ашытқы саңырауқү-лақтар спирт пен көмір қышқыл газын түзеді. Бұл процесті мьша-дай схемамен көрсетуге болады.

Крахмал+ амилаза ферменттері ->мальтоза қанты мальтаза ферменті-^ глюкоза; глюкоза қанты + зимаза ферменттері -> этил спирті және көмір қышқыл газы. Спирттік ашу процесінің табиғаты терең зерттелді. Бүған көп еңбек сіңірген және бірқатар жаңалықтар қосқан орыс оқымысты-лары Л. А. Иванов, С. П. Костычев, А. Н. Лебедев, А. Н. Бах, В. И. Палладин, В. А. Энгельгард, шетел ғалымдары Нейберг, Мейергоф, Гарден, Эмбденді атап өткен жөн. Осы ғалымдардың еңбектерінің арқасында спирттік ашу процесініқ ішкі сыры, басқаша айтқанда, химиясы төмендегіше болатыны анықталды. * Бұл процестің бірінші сатысында глюкоза қанты фосфор қышқылымен қосылып, глюкозофосфат эфиріне айналады. Бүл реакцияға ашыт-қы саңырауқұлақтар клеткаларында кездесетін АТФ қатынасады
Бүл қосылыс өзінен фосфор қышқылын бөліп қантқа береді, соның нәтижесінде АДФ-ға айналады. Осы жағдайда өтетін бірнеше ре-акциялардың нәтижесінде глюкоза фруктоза қантына айналады. Бұл реакциялар барысында глюкофосфатизомераза, фосфофрукто-киназа ферменттері қатысады. Пайда болған соңғы фруктоза моле-куласы құрамында - әуелі бір, соңынан екінші фосфор қышқылы қосылады.

Реакцияның осы сатысына дейін қант молекуласы бүзылмастан, тұтас күйінде, тек активті жағдайда болады. Бұдан кейін дифосфорлы фруктоза қанты альдолаза ферментінің көмегімен екіге бөлінеді. Сөйтіп, фосфоглицериндік альдегид және фосфодиоксиацетон деген екі зат пайда болады. Бүдан кейін изомераза ферментінің әсерінен фосфодиоксиацетон әрдайым фосфоглицериндік альдегидке айналып отырады. Бұл төмендегіше жүреді: Б. ұдан кейін 3-фосфоглицериндік альдегид триозофосфатдеги-дрогеназа (Н5 - ферменті) ферментінің қатысуымен минералдық фосфор қышқылымен реакцияға түседі. Осының нәтижесінде пайда болған өнімдер дегидрогеназа ферментінің әсерінен тотығып, яғни екі атом сутегін бөліп шығарып, төмендегі ретпен 1, 3-дифосфоглицерин қышқылына айналады.

СН3►СН3С=ОНАД-Н2+ НИ этилспирті ұт қышқылы ашу немесе жануарлар бұлшық етінде жүретін гликолиз процесінде, оттегінің тапшылығынан, пирожүзім қышқы-лы лактатдегидрогеназа ферменті әсерінен екі атом сутегін қосып алып, төмендегі, реакция арқылы сүт қышқылына айналады. сн3сн3 С-0 +НАД = Н2> СНӨН+НАДI(Лактатдеидрогеназы) 1соонсоон пирожүзім сүт қышқылықышқылы. Аэробтық, яғни оттегі мол болғанда пирожүзім қышқылы, тыныс алу процесінде түгелдей тотығып, су және көмір қышқыл газына айналады: СНзСОСООН+5О-^ЗСО2 + 2Н2О Спирттік ашу процесінің тұрмыста үлкен маңызы бар, ейткені оның нәтижесінде тамақ өндірісі, адамға керекті әр түрлі арақшарап ішімдіктері даярланады. Жүзім шырынынан - шарап, коньяк жасалады, қамыс қантынан - ром, арақ; крахмалға бай дәндерден (арпа, жүгері, бидай) -сыра, квас, виски, аракі; күріш пен тарыдан - сака деген шарап, боза, кәже және тағы басқаларды даярлайды.

Ашу процесі дүрыс жүру үшін, көптеген жағдайлар - қант концентрациясы, орта қышқылдығы (рН), температура және жиналған спирт мөлшері керек. Ашытуға алынған қанттың концентрациясы 15%-тей болу керек. Қант мөлшері бүдан артық болса, ашытқы саңырауқүлақтардың тіршілік ету қабілеті темендейді. Кейде ортадағы қант 60% болғанда да ашыта алатын ашытқы саңырауқүлақтары болады. Ашу процесі орта қышқылдығы (рН) 4, 0 немесе 4, 5-ке тең болғанда қалыпты жүреді. Ашу процесі барысында ортада жиналған спирт аса көп болса, ашытқы саңырауқүлақтарына қолайсыз әсер етеді. Орта көлемінің 15%-дей мөлшерінде спирт жиналғанда ашу процесі тоқталады. Бірақ соңғы жылдардағы зерттеулерге қарағанда ортадағы спирттің концентрациясы 20-25%-тей болғанда да тіршілік ететін ашытқы саңырауқүлақтардың бар екені анықталды. Орта реакциясы сілтілі болғанда спирт орнына ортада глицерин мен сірке қышқылы түзіледі.

Ашудын, ең қолайлы температурасы +28-32°. Температура + 50°-қа дейін жоғарылағанда ашу тоқталады. Ал төменгі температурада ашу процесінің қарқыны баяулайды, бірақ мүлде тоқтап калмайды. Спирттік ашу процесі әдетте анаэробты жағдайда жақсы жүреді. Сонымен қатар ауаны жеткілікті мөлшерде жібергенде ашытқы саңырауқұлақтардың саны тез өсетіні белгілі. Сондықтан нан ашытқы саңырауқұлақтарды өсіргеыде ыдысқа дамылсыз ауа енгізіп отырады. Осыған байланысты беттік және түптік ашу деп бөлінеді. Беттік ашу процесі +14-24°-та жақсы жүреді. Мұнда ортадан көп мөл-шерде газ бөлінеді. Беттік ашу көбінесе шарап жасауда және нан өндірісінде қолданылады. Ашу процесі толық аяқталғаннан кейін ашытқы саңырауқұлақтар сүйық түбіне түнып қалады.

- Іс жүргізу
- Автоматтандыру, Техника
- Алғашқы әскери дайындық
- Астрономия
- Ауыл шаруашылығы
- Банк ісі
- Бизнесті бағалау
- Биология
- Бухгалтерлік іс
- Валеология
- Ветеринария
- География
- Геология, Геофизика, Геодезия
- Дін
- Ет, сүт, шарап өнімдері
- Жалпы тарих
- Жер кадастрі, Жылжымайтын мүлік
- Журналистика
- Информатика
- Кеден ісі
- Маркетинг
- Математика, Геометрия
- Медицина
- Мемлекеттік басқару
- Менеджмент
- Мұнай, Газ
- Мұрағат ісі
- Мәдениеттану
- ОБЖ (Основы безопасности жизнедеятельности)
- Педагогика
- Полиграфия
- Психология
- Салық
- Саясаттану
- Сақтандыру
- Сертификаттау, стандарттау
- Социология, Демография
- Спорт
- Статистика
- Тілтану, Филология
- Тарихи тұлғалар
- Тау-кен ісі
- Транспорт
- Туризм
- Физика
- Философия
- Халықаралық қатынастар
- Химия
- Экология, Қоршаған ортаны қорғау
- Экономика
- Экономикалық география
- Электротехника
- Қазақстан тарихы
- Қаржы
- Құрылыс
- Құқық, Криминалистика
- Әдебиет
- Өнер, музыка
- Өнеркәсіп, Өндіріс
Қазақ тілінде жазылған рефераттар, курстық жұмыстар, дипломдық жұмыстар бойынша біздің қор #1 болып табылады.



Ақпарат
Қосымша
Email: info@stud.kz